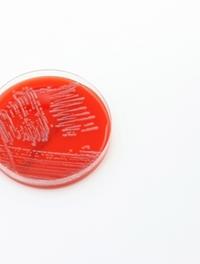

Pneumonie sévère à pneumocoque : qui développe une méningite ?
La pneumonie communautaire est la première cause d'admission en unité de soins intensifs (USI) et de mortalité par maladies infectieuses. Streptococcus pneumoniae est le principal agent responsable de pneumonie communautaire nécessitant une admission en USI. Il peut être à l'origine d’un syndrome de détresse respiratoire aiguë (SDRA) et d’une pneumococcie invasive, grevés d’un taux de mortalité élevé. Ces malades peuvent développer une méningite. Dans l’hypothèse où [...]